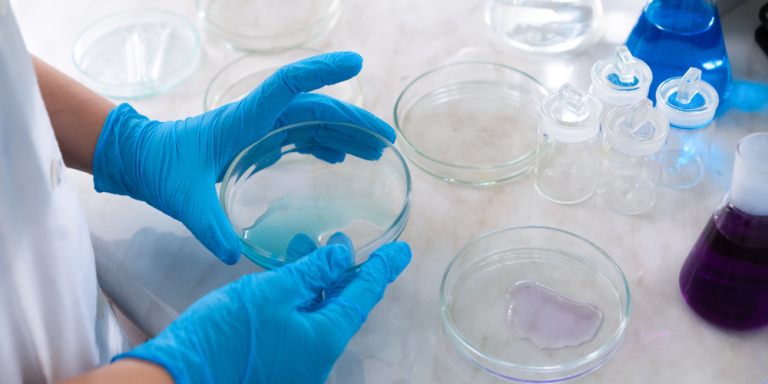

Por qué es importante la atención centrada en el paciente
Una explicación clara sobre la atención centrada en el paciente y el papel de la investigación clínica para hacerla posible.

Una explicación clara sobre la atención centrada en el paciente y el papel de la investigación clínica para hacerla posible.

Lo que parecía un asma sin solución cambió para Martina gracias a los ensayos clínicos, que le devolvieron el control de su vida.

Una guía sencilla y accesible para comprender el mundo de los ensayos clínicos y familiarizarte con su terminología clave.

Un hospital en Barcelona implanta el marcapasos más pequeño del mundo a una recién nacida prematura de tan solo 2,1 kilos.

Descubre los 11 ensayos clínicos que podrían cambiar la forma en que prevenimos y tratamos las enfermedades en 2026.

Ante los avances en cáncer de páncreas, los expertos recuerdan que la investigación exige tiempo, evidencia y rigor.
La investigación clínica en España lidera en la UE y acerca a los pacientes a tratamientos innovadores.

¿Alguna vez has deseado contribuir al futuro de la medicina? ¡Regístrate hoy mismo!

2025 demuestra que la ciencia sigue impulsando avances que transforman la salud global.

La ciencia revela que las canas podrían estar relacionadas con un mecanismo de protección contra el cáncer.

Unimos fuerzas con ANADI para mejorar la vida de personas con diabetes.

Programa de 4 semanas con herramientas sobre alimentación, ejercicio y bienestar emocional, accesibles desde el móvil u ordenador.

Un avance científico en España logra salvar a niños con leucemia y abre una nueva era de esperanza.

Tras años conviviendo con asma severo, Carmen decidió participar en un estudio clínico, cambiando su vida.

En esta ocasión, nuestra especialista de comunidades, Sierra, entrevistó a una persona que participó en un ensayo clínico sobre microbiota.
El registro y la membresía con nosotros son completamente gratuitos y muy sencillos. Para unirse, solo tiene que hacer clic en el botón “Registro”, ubicado en la esquina superior derecha de la página, y seguir las instrucciones que aparecerán.
Lamentablemente no; necesitamos poder ponernos en contacto con usted por correo electrónico.
No, la Comunidad de Investigación no precisa de ningún requisito concreto de salud para su membresía.
No, solo es necesario que complete nuestro formulario de alta con sus datos de contacto. Sin embargo, para poder ofrecerle ensayos clínicos que realmente se ajusten a su perfil, le recomendamos completar también el Cuestionario General de Salud. Este cuestionario nos permite conocer mejor su situación y evitar enviarle información que no sea relevante para usted.
Sí, puede retirar su participación en un ensayo clínico en cualquier momento.